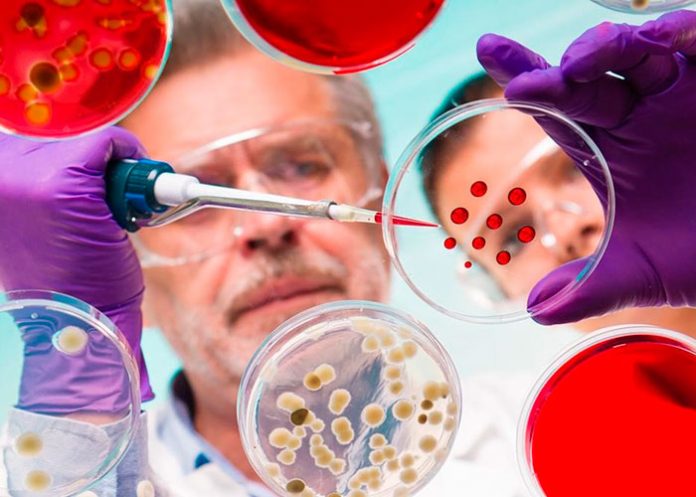
microbios buenos

La creación de una reserva mundial de microbioma humano, un "Arca de Noé" de microbios buenos, puede ser el antídoto ante la crisis global de salud que refleja el aumento de enfermedades como la obesidad, el asma o las alergias, según plantea un grupo de investigadores.
Liderados por un equipo de la Universidad de Rutgers, en Nueva Jersey (EE.UU.), los investigadores comparan su propuesta, detallada en el último número de la revista Science, con la Bóveda Global de Semillas de Svalbard, la mayor reserva mundial de muestras de cultivos alimentarios.
Inaugurado en febrero de 2008 en el archipiélago noruego de Svalbard, en el Circulo Polar Ártico, ese depósito tiene capacidad para albergar un total de 4,5 millones de muestras.
La microbiota ha evolucionado conjuntamente con los seres humanos, y con animales y plantas, durante milenios.

Algunos órganos del cuerpo humano "no funcionan normalmente sin los microbios asociados", que ejercen distintas funciones, "desde entrenar al sistema inmune hasta digerir alimentos y producir vitaminas", explicó a EFE la venezolana María Gloria Domínguez-Bello, autora principal de la propuesta y profesora de la Universidad de Rutgers.
Desde hace varias generaciones, los antibióticos y las dietas procesadas han contribuido a una pérdida masiva de la diversidad microbiana.
Te puede interesar: El medicamento común que podría salvar tu vida en un infarto
"Las prácticas modernas gracias a las que hemos controlado las enfermedades infecciosas parecen estar teniendo el efecto colateral de afectar a nuestros microbios humanos", precisó Domínguez-Bello, quien agregó que también "impiden la transmisión de microbios buenos, sobre todo a los bebés".

Y las evidencias científicas revelan, cada vez con más contundencia, que las alteraciones de la microbiota durante los primeros años de vida y las anomalías metabólicas resultantes son factores clave para el desarrollo de enfermedades.
Por ello, Domínguez-Bello y los coautores del artículo, Rob Knight, de la Universidad de California-San Diego (EE.UU.); Jack A. Gilbert, de la Universidad de Chicago (EE.UU.), y Martin J. Blaser del Centro Médico Langone de la Universidad de Nueva York, plantean la necesidad de reintroducir microbios perdidos y crear una reserva mundial de microbioma.
El primer paso sería, según señalan en el artículo, recolectar microbios beneficiosos de poblaciones remotas de América Latina y África, que son las que mantienen una mayor diversidad microbiana porque todavía no han sido víctimas de los efectos nocivos de las sociedades modernas y urbanizadas.

Como ejemplo, la flora intestinal de la mayoría de los estadounidenses es la mitad de diversa que la de los cazadores de pueblos aislados de la Amazonía.
Una vez identificados, los "microbios saludables" podrían ser "reintroducidos como probióticos" o como "una especie de 'vacunación' usando componentes activos, pero no para proteger contra patógenos sino para obtener la función beneficiosa", indicó Domínguez-Bello.
Los investigadores subrayan que es imprescindible un esfuerzo internacional, con financiación suficiente, para recolectar y almacenar los microbios buenos en una reserva global.
El artículo "es el primer paso para hacer visible la idea y poder comenzar la campaña de apoyo", concluyó Domínguez-Bello.
Fuente: EFE